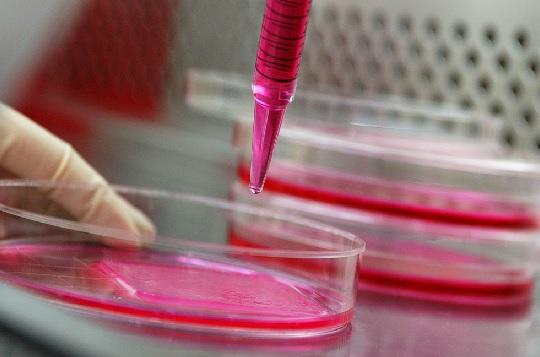

Press release
Cell based Assays Market: An Extensive Analysis Predicts Significant Future Growth
The "Cell based Assays Market" intelligence report, just published by USD Analytics, covers a micro-level study of important market niches, product offers, and sales channels. To determine market size, potential, growth trends, and competitive environment, the Cell based Assays Market provides dynamic views. Both primary and secondary sources of data were used to generate the research, which has both qualitative and quantitative depth. Several of the major figures the study featured include AAT Bioquest Inc, Becton, Dickinson and Company, BellBrook Labs LLC, BioAgilytix Labs LLC, BMG LABTECH GmbH, BPS Bioscience Inc, CA3 Biosciences Inc, Carna Biosciences Inc, Cell Biolabs Inc, Cell Signaling Technology Inc, Charles River Laboratories International Inc, Danaher Corp, Enzo Biochem Inc, Eurofins Scientific SE, Hanugen Therapeutics Inc, InvivoGen, JRS Pharma LP, Lonza Group Ltd, Merck KGaA, PerkinElmer Inc, Pestka Biomedical Laboratories Inc, Profacgen, Promega Corp, Reaction Biology Corp, Thermo Fisher Scientific Inc, and Others.Get Sample Report + All Related Graphs & Charts @: https://www.usdanalytics.com/sample-request/9126
Cell based Assays Market is estimated to increase at a Compounded Annual Growth Rate of 9.1% CAGR over the forecast period from 2024 to 2032.
An Overview of the Cell based Assays Market
The cell-based assays market is experiencing significant growth, driven by the increasing demand for advanced drug discovery and development techniques, as well as the rising focus on personalized medicine and biotechnology research. Cell-based assays are crucial for understanding biological processes, evaluating drug efficacy, and determining toxicity in a more physiologically relevant context compared to traditional biochemical assays. The market is supported by advancements in high-throughput screening technologies, the growing adoption of 3D cell culture models, and the expanding use of cell-based assays in cancer research, stem cell research, and regenerative medicine. Innovations in assay development, such as the integration of automation, imaging, and data analysis tools, are enhancing the efficiency and accuracy of cell-based assays, driving their widespread adoption in pharmaceutical and biotechnology companies. Additionally, the increasing emphasis on reducing animal testing and improving the predictability of preclinical studies is further contributing to market growth. As the need for more sophisticated and reliable testing methods continues to grow, the cell-based assays market is poised for sustained expansion, supported by ongoing technological advancements and the increasing complexity of biological research.
Cell based Assays Market Size, Share, Trends, Growth Outlook, and Opportunities to 2032- By Products and Services (Reagents, Assay Kits, Microplates, Probes & Labels, Instruments & Software, Cell Lines), By Application (Basic Research, Drug Discovery, Other Applications), By End-User (Pharmaceutical & Biotechnology Companies, Academic & Research Institutes, Contract Research Organizations (CROs)), and significant players are the market segments.
In order to provide a thorough analysis of the industry, the report compiled data from over 22 jurisdictions or nations across Europe, North America, South America, Asia Pacific, and MEA.
Geographically, the global version of the report has the following country inclusion:
• North America [United States, Canada, and Mexico]
• Europe [Germany, the UK, France, Italy, Netherlands, Belgium, Denmark, Spain, Sweden, and the Rest of Europe]
• Asia-Pacific [China, Japan, South Korea, India, Australia, Indonesia, and Others]
• South America [Brazil, Argentina, Colombia, and the Rest of South America]
• the Middle East and Africa (South Africa, Turkey, Israel, GCC Countries, and the Rest of Africa)
Enquire for customization or check for any discount if available @: https://www.usdanalytics.com/discount-request/9126
The primary goal of this study is to determine which market niches or nations that companies and investors should concentrate on in the future in order to allocate their resources and efforts toward Cell based Assays that will optimize growth and profitability. The year 2024 will see notably slower growth, and given the dynamic macroeconomic and regulatory environment, major markets in North America and Western Europe will need "heavy lifting" to handle these tendencies.
In the Cell based Assays industry, distribution channels are always crucial because of the "push" nature of many offerings in the sector. In an effort to strengthen their relationship with customers, companies have been refining their distribution models. As the Internet becomes more widely used and consumers start to value expediency, digital purchases are growing in popularity in Cell based Assays.
Furthermore, the years considered for the study are as follows:
Historical year - 2018-2023
Base year - 2023
Forecast period** - 2024 to 2032 [** unless otherwise stated]
Access Cell based Assays Market Report Now; Buy Latest @: https://www.usdanalytics.com/payment/report-9126
Major Highlights of TOC:
Chapter 1: Overview of the Cell based Assays Market Industry
1.1.1 Overview
1.1 Cell based Assays Industry
1.1.2 Key Companies' Products
1.2 Market Segment by Cell based Assays
1.2.1 Industry Chain
1.2.2 Customer Behavior & Distribution Routes
Chapter Two: Demand for Cell based Assays Worldwide
2.1 Overview of the Segment
2.2 Cell based Assays Market Size (2018-2023) by Application/End Users
2.3 Application/End User Forecast for the Cell based Assays Market (2024E-2032)
Chapter 3: Type-wise Cell based Assays Market
3.1 According to Type
3.2 Market Size for Cell based Assays by Type, 2018-2023
3.3 Market Forecast for Cell based Assays by Type (2024E-2032)
Chapter Four: Cell based Assays Market: by Region/Country
4.1 Cell based Assays Market by Regions
4.2 Cell based Assays Market Revenue & Share by Region
4.3 North America
4.4 Europe
4.5 Asia Pacific
4.6 South America
4.7 the Middle East & Africa
Player Analysis in Chapter Five
5.1 Players' Market Share Analysis (2023)
5.2 Regional Market Concentration Rates
5.3 Overviews of Companies
..........continued
Browse Executive Summary and Complete Table of Content @: https://www.usdanalytics.com/industry-reports/cell-based-assays-market
Thanks for reading this article; you can also get individual chapter wise section or region wise report version like North America, Middle East, Africa, Europe or LATAM, Southeast Asia.
Contact Us:
Harry (Business Consultant)
USD Analytics Market
Phone: +1 213-510-3499
sales@usdanalytics.com
USD Analytics is a leading information and analytics provider for customers across industries worldwide. Our high-quality research publications are connected market. Intelligence databases and consulting services support end-to-end support our customer research needs.
This release was published on openPR.
Permanent link to this press release:
Copy
Please set a link in the press area of your homepage to this press release on openPR. openPR disclaims liability for any content contained in this release.
You can edit or delete your press release Cell based Assays Market: An Extensive Analysis Predicts Significant Future Growth here
News-ID: 3617838 • Views: …
More Releases from USD Analytics
Commercial Vehicle Telematics Market Is Booming So Rapidly | Gurtam, Teletrac Na …
The Global Commercial Vehicle Telematics Market Size is estimated at $7.1 Billion in 2025 and is forecast to register an annual growth rate (CAGR) of 13.6% to reach $22.4 Billion by 2034.
The latest study released on the Global Commercial Vehicle Telematics Market by USD Analytics Market evaluates market size, trend, and forecast to 2034. The Commercial Vehicle Telematics market study covers significant research data and proofs to be a handy…
Wind Turbine Operations and Maintenance Market Is Booming So Rapidly | Vestas, N …
The Global Wind Turbine Operations and Maintenance Market Size is estimated at $18.2 Billion in 2025 and is forecast to register an annual growth rate (CAGR) of 7.4% to reach $34.6 Billion by 2034.
The latest study released on the Global Wind Turbine Operations and Maintenance Market by USD Analytics Market evaluates market size, trend, and forecast to 2034. The Wind Turbine Operations and Maintenance market study covers significant research data…
Solar Trackers Market Is Booming So Rapidly | , Soltec, SunPower, Valmont
The Global Solar Trackers Market Size is estimated at $6.2 Billion in 2025 and is forecast to register an annual growth rate (CAGR) of 24.5% to reach $44.6 Billion by 2034.
The latest study released on the Global Solar Trackers Market by USD Analytics Market evaluates market size, trend, and forecast to 2034. The Solar Trackers market study covers significant research data and proofs to be a handy resource document for…
Aircraft Sensors Market Is Booming So Rapidly | Meggitt, Esterline, Indra
The Global Aircraft Sensors Market Size is estimated at $6.9 Billion in 2025 and is forecast to register an annual growth rate (CAGR) of 4.3% to reach $10.1 Billion by 2034.
The latest study released on the Global Aircraft Sensors Market by USD Analytics Market evaluates market size, trend, and forecast to 2034. The Aircraft Sensors market study covers significant research data and proofs to be a handy resource document for…
More Releases for Cell
Cell Sorting Market Accelerates as Cell Therapy, Immuno-Oncology & Single-Cell R …
The rising focus on precision medicine, immunotherapy, and advanced cell-based research is driving the global cell sorting market into a high-growth phase. With expanding applications in stem cell therapy, CAR-T manufacturing, cancer immunology, and single-cell genomics, demand for accurate, high-purity cell isolation systems is stronger than ever. This release highlights key market trends, segmentation insights, technological innovations, and the factors shaping the future of cell sorting.
Download Full PDF Sample Copy…
Cell Isolation Cell Separation Market Size Analysis by Application, Type, and Re …
According to Market Research Intellect, the global Cell Isolation Cell Separation market under the Internet, Communication and Technology category is expected to register notable growth from 2025 to 2032. Key drivers such as advancing technologies, changing consumer behavior, and evolving market dynamics are poised to shape the trajectory of this market throughout the forecast period.
The market for cell isolation and separation is expanding rapidly as a result of sophisticated biotechnological…
Cell Free Protein Synthesis Market Beyond the Cell: Revolutionizing Protein Prod …
Cell-Free Protein Synthesis Market to reach over USD 457.13 Mn by the year 2031 - Exclusive Report by InsightAce Analytic
"Cell-Free Protein Synthesis Market" in terms of revenue was estimated to be worth $265.94 Mn in 2023 and is poised to reach $457.13 Mn by 2031, growing at a CAGR of 7.20% from 2024 to 2031 according to a new report by InsightAce Analytic.
Request for free Sample Pages: https://www.insightaceanalytic.com/request-sample/1445
Current…
Cell Expansion Market - Expand the Boundaries of Cell Therapy: Redefine Cell Exp …
Newark, New Castle, USA: The "Cell Expansion Market" provides a value chain analysis of revenue for the anticipated period from 2022 to 2030. The report will include a full and comprehensive analysis of the business operations of all market leaders in this industry, as well as their in-depth market research, historical market development, and information about their market competitors
Cell Expansion Market: https://www.growthplusreports.com/report/cell-expansion-market/7939
This latest report researches the industry structure, sales, revenue,…
Global GMP Cell Banking Market By Type - Mammalian Cell, Microbial Cell, Insect …
Researchmoz added Most up-to-date research on "Global GMP Cell Banking Market By Type - Mammalian Cell, Microbial Cell, Insect Cell and Others" to its huge collection of research reports.
This report researches the worldwide GMP Cell Banking market size (value, capacity, production and consumption) in key regions like North America, Europe, Asia Pacific (China, Japan) and other regions.
This study categorizes the global GMP Cell Banking breakdown data by manufacturers, region, type…
Cell Culture Market Size, Cell Culture Market Share, Cell Culture Market Trends …
According to a new research published by Polaris Market Research the global cell culture market is anticipated to reach more than USD 49 billion by 2026. Cell culture is a rapidly emerging as an implement for analyzing and treating various disease such as Alzheimer’s and cancer.
Request for Sample of This Research Report @ https://bit.ly/2D7pZ5u
Top Key Players: -
Becton,
Dickinson and Company
Biospherix
EMD Millipore
Eppendorf AG
Merck KGaA
Sartorius AG
VWR International
Cell culture is a rapidly emerging…